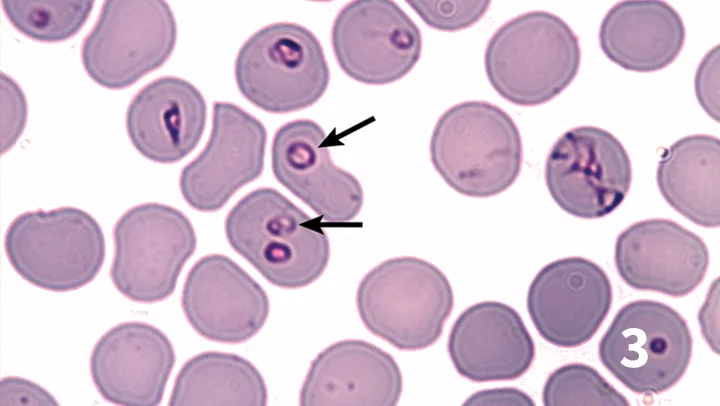
Featured Image

Top 5 Transplacental Parasitic Infections in Dogs
Dwight D. Bowman, MS, PhD, Cornell University

In dogs, parasites that infect the fetus transplacentally may cause life-threatening disease in the fetus and newborn. Transplacental transmission also allows vector-borne diseases to cycle when vectors are not active or present in a geographic area and can contribute to introduction and establishment of parasites where they previously did not occur. This mode of transmission is well-known for some parasites (eg, Toxocara canis) and more recently shown to occur with others (eg, Leishmania infantum).
1. Toxocara canis
Puppies infected in utero by massive numbers of reactivated T canis larvae in the bitch sometime after the 42nd day of pregnancy are at risk for obstruction and rupture of the intestine.1 Rupture can lead to peritonitis that may be exacerbated by continued release of eggs into the peritoneal cavity. Puppies can be presented with inappetence, depression, diarrhea, weakness, ascites, failure to thrive, cachexia, and signs similar to those of rickets (eg, difficulty rising, bowed limbs, stiff gait). Young adult worms may be found in the peritoneal cavity, bile ducts, and even the liver parenchyma. The typical pressure-sensitive, drum-shaped abdomen may occur as well. Puppies with large numbers of prenatal T canis will have decreased erythrocyte numbers, mostly caused by severe internal bleeding from preadults migrating through the liver and intestinal rupture; when only moderately infected, puppies will show an increase in erythrocytes from the fifth week of life onward.1 Eosinophilia is observed in prenatally infected puppies beginning 7 days postpartum.1 Liver enzymes (ie, glutamate dehydrogenase [GLDH] and alanine transaminase [ALT]) are elevated at birth.1 Enzyme levels return to normal values 1 to 2 weeks postpartum.1 Prenatal infection almost guarantees that puppies will be infected with T canis at birth.

Tissue press of murine brain tissue showing an infective third-stage larva of Toxocara canis
Management
No anthelmintics are registered in the United States for prevention of transplacental transmission of T canis. Macrocyclic lactones have demonstrated efficacy against reactivated larvae in pregnant dogs.2 Moxidectin reliably prevents T canis infections in puppies after 2 SC applications on days 40 and 55 of pregnancy.3,4 Ivermectin and doramectin can also be efficacious at high dosages. Fenbendazole is labeled in the United Kingdom for prevention of transplacental transmission of T canis but only when administered daily from day 40 of pregnancy until parturition.5
Related Article: Differentiation of Parasites & Pseudoparasites
2. Neospora caninum
When prenatally acquired, infection with Neospora caninum (ie, neosporosis) can result in a progressively worsening polyradiculitis, often leading to fatal paralysis.6-8 Signs can begin at 3 to 9 weeks of age and typically appear in dogs younger than 6 months of age presented with ascending paralysis of the limbs. Neosporosis is characterized by ascending paralysis associated with gradual muscle atrophy and stiffness that usually affects the pelvic limbs more than the thoracic limbs. Paralysis progresses to rigid contracture of the muscles of the affected limb. Occurring arthrogryposis is caused by scar formation in the muscles from lower motor neuron damage and myositis. Some puppies may develop joint deformation and genu recurvatum. Cervical weakness, dysphagia, megaesophagus, and death can occur. Dogs do not develop severe intracranial manifestations and maintain alert attitudes. They can survive for months with hand-feeding and care but remain paralyzed with associated complications.

Tissue press of brain tissue from a naturally infected dog showing a cyst (arrow) containing bradyzoites of Neospora caninum
Suppositions are that during gestation, the chronically and subclinically infected bitch develops parasitemia, which spreads transplacentally to the fetus, and successive litters may be born infected. However, transplacental transmission alone is unlikely to propagate N caninum infection in dogs in nature.9 Most puppies in a litter have clinical manifestations; others may carry the infection subclinically, with reactivation occurring later in life because of immunosuppressive illnesses, administration of modified live virus vaccines, or glucocorticoids.
Management
Treatment will likely not lead to improvement in puppies already showing advancing paralysis or muscle contracture. However, if 1 puppy in a litter is diagnosed with infection, it is prudent to treat the entire litter with clindamycin, sulfadiazine, and pyrimethamine, alone or in combination.10 At this time, potential benefits of ponazuril on affected neonates are unclear.
Related Article: Pediatric Critical Care
3. Babesiosis
Both Babesia canis and Babesia gibsoni are known to be transmitted transplacentally in dogs.11 B canis, the species with a large intracellular trophozoite, was diagnosed in a litter of 3-week-old mastiffs that came from a tick-infested kennel housing 30 dogs.12 Clinical signs seen in the puppies included lethargy, poor body condition, pale and icteric mucous membranes, splenomegaly, tachycardia, heart murmur, anemia, and thrombocytopenia. The puppies responded well to treatment with intramuscular diminazene aceturate at 3 mg/kg. Organisms were not seen in the blood of the mother, although she was seropositive on an immunofluorescent assay.
Giemsa-stained blood film showing red blood cells parasitized by Babesia gibsoni (arrows)
B gibsoni, the species with the small intracellular trophozoite, has been transmitted experimentally to puppies in Japan.13 An adult female dog that had been experimentally infected 2 years before mating gave birth to 1 stillborn puppy and 4 living puppies, which died of congenital babesiosis between 14 and 39 days postpartum.
Management
Puppies typically respond well to treatment with antibabesial drugs (eg, imidocarb dipropionate, diminazene aceturate).14 An atovaquone and azithromycin combination reportedly is more effective for B gibsoni infections.15
Related Article: Diagnosing & Treating Babesiosis in Dogs
4. Leishmaniasis
Leishmania infantum (L chagasi) infection was identified in several thousand foxhounds throughout 18 US states and 2 Canadian provinces.16 Efficient sandfly vectors were not found, and transplacental transmission for canine leishmaniasis was suspected.16-24 Infected puppies can be presented with nonregenerative anemia, mild thrombocytopenia, mild hyponatremia, and signs of hepatocellular injury. Infected dogs typically have hyperproteinemia attributed to hypergammaglobulinemia. Urinalysis will often show proteinuria.

Giemsa-stained impression smear from canine splenic tissue showing a macrophage (red arrow) with numerous amastigotes (blue arrows) of Leishmania infantum
Management
Sodium stibogluconate can suppress and sometimes cure infection. However, although clinical improvement may occur, relapses are common, and chemotherapeutic elimination of L infantum has not been consistently achieved with any drug tested to date.
Related Article: Canine Leishmaniasis: An Overview
5. Dirofilarial microfilariae
Puppies born to mothers with patent infections of the heartworm Dirofilaria immitis or heartworms subcutaneous relative D repens outside North America will often have circulating microfilariae in their blood at birth.25-28 Although these infections in puppies are without direct medical significance, they can often be detectable at the time of a microfilarial test 6 months after birth. These microfilariae do not develop further and expire in 1 to 2 years if not first cleared by microfilaricidal therapy. Theoretically, these microfilariae could develop further if ingested by a mosquito and serve as of reservoir of infection for other dogs.

Giemsa-stained microfilaria of Dirofilaria immitis in a peripheral blood smear
Management
Microfilariae-positive neonatal puppies should be started on heartworm preventive therapy and monitored to ensure the microfilariae clear as expected.
Related Article: Canine Heartworm: Positive Result Despite Prevention
Conclusion
The infections discussed are common in the United States. Although few parasites infect dogs transplacentally, vertical transmission may allow for more widespread prevalence of these infections.
ALT = alanine transaminase, GLDH = glutamate dehydrogenase